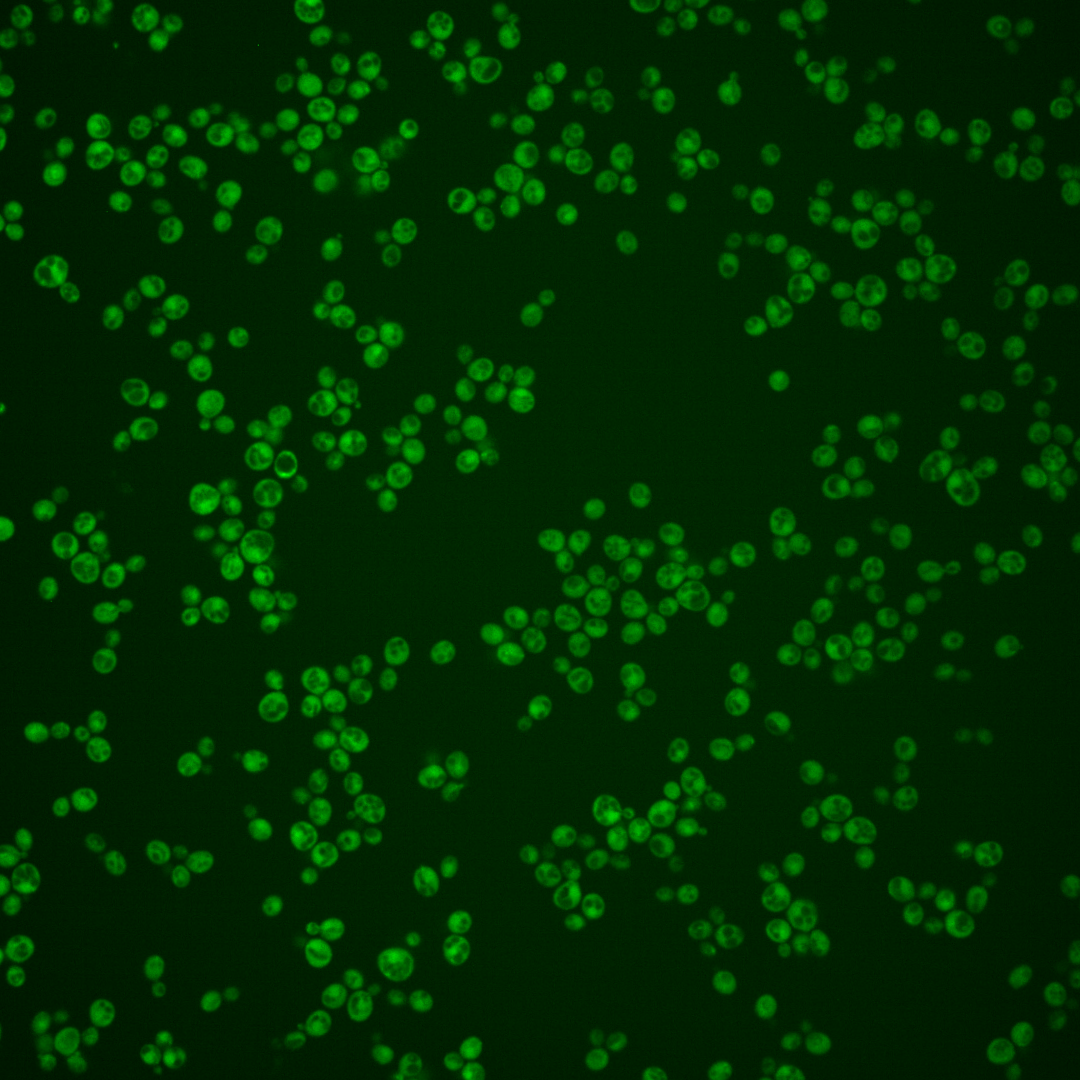
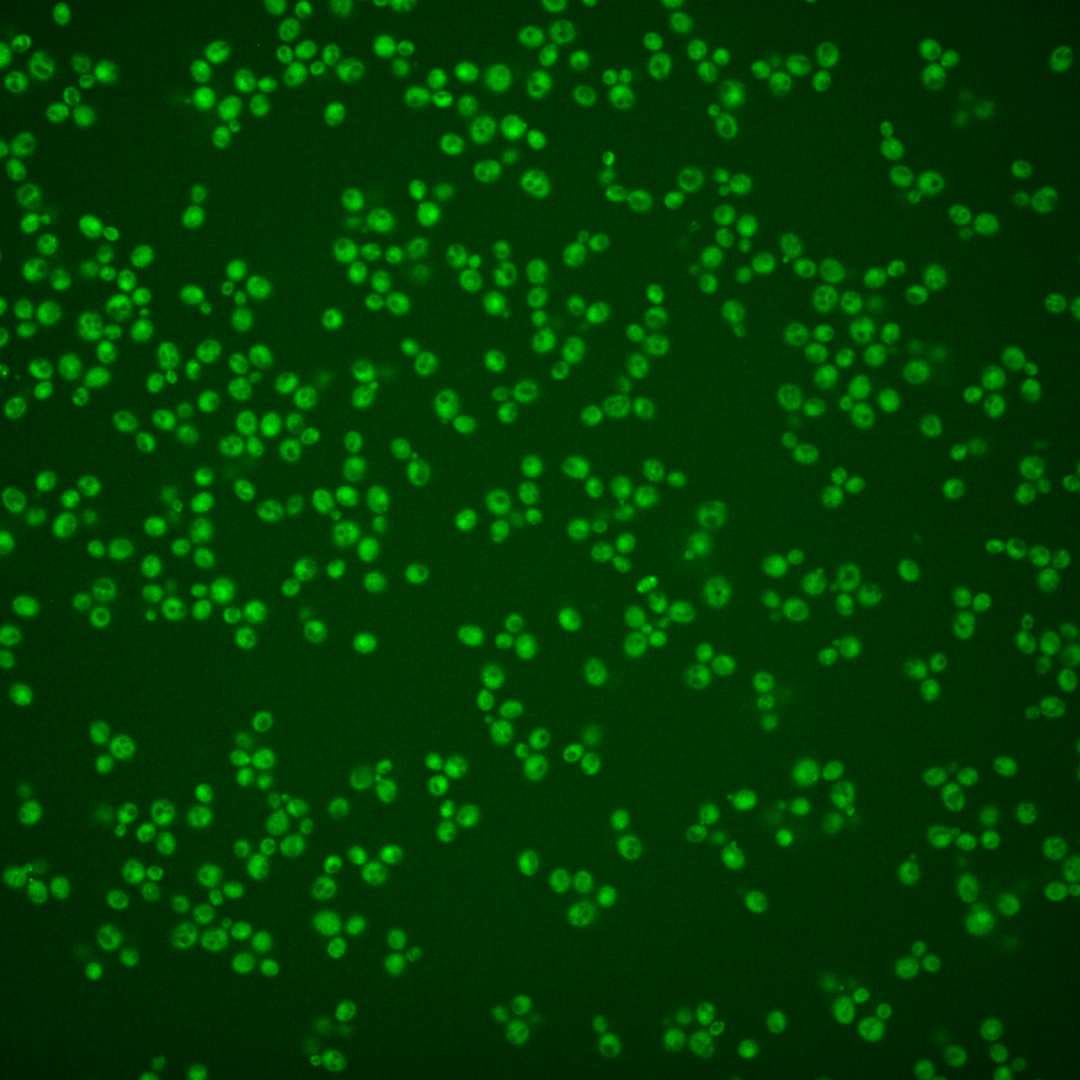
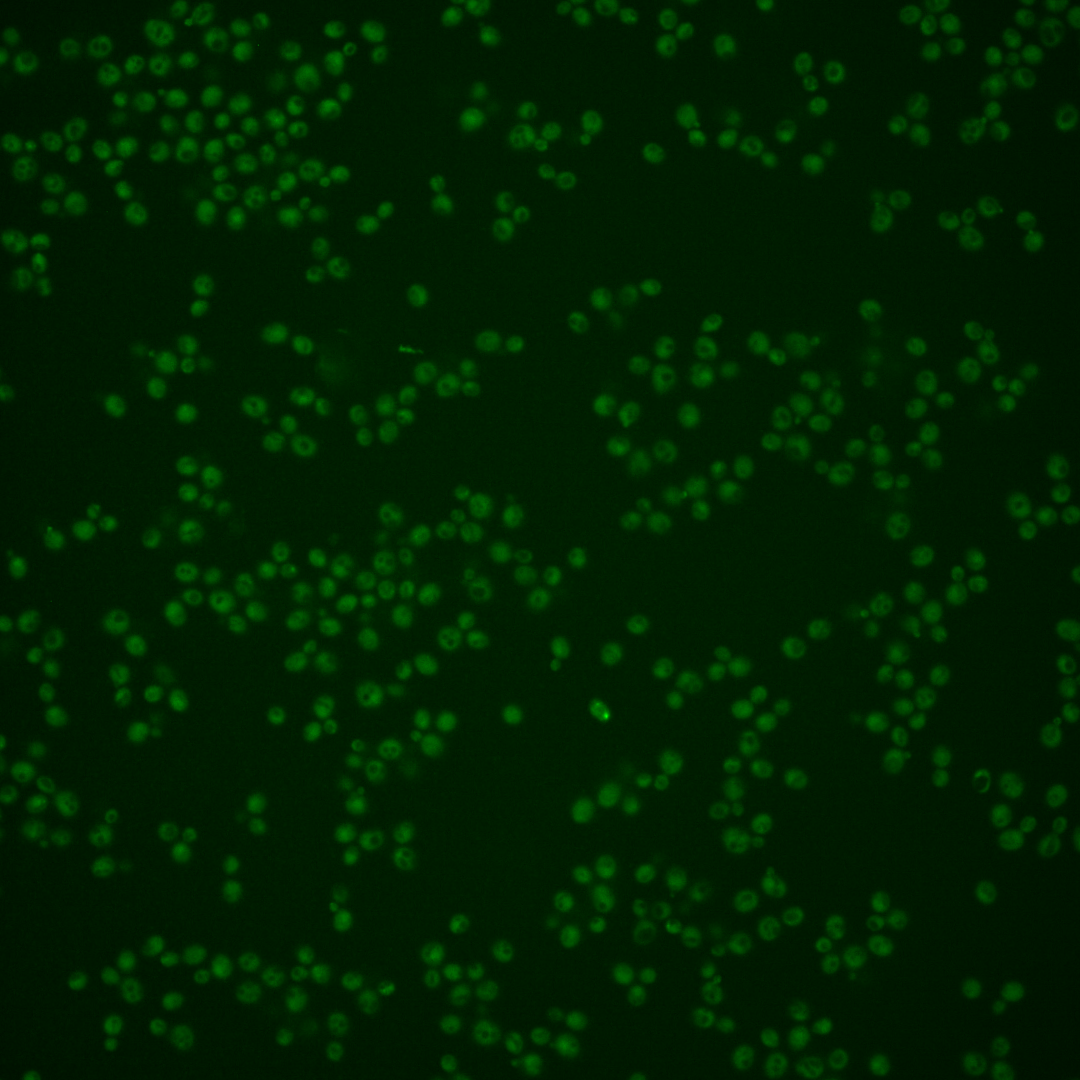
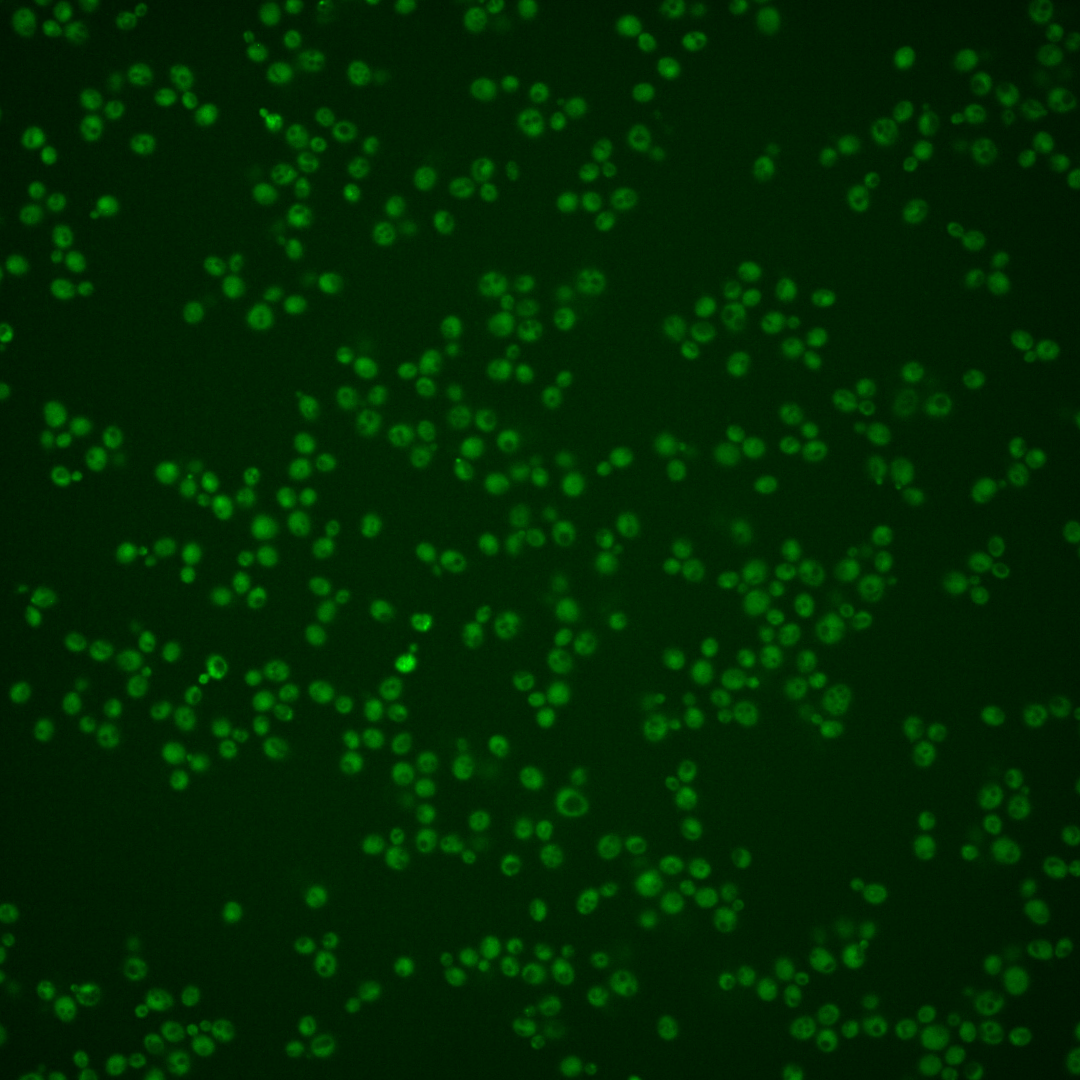
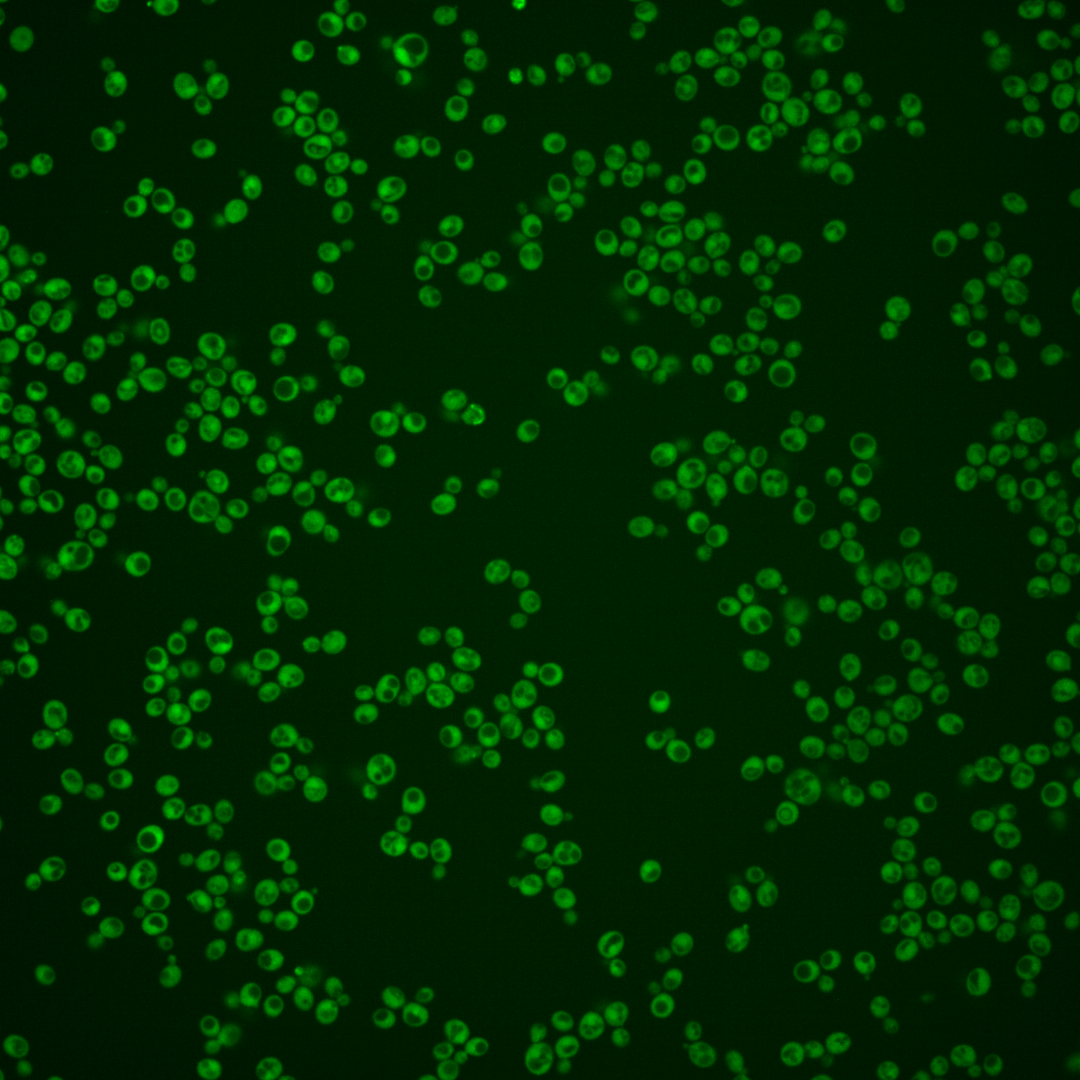
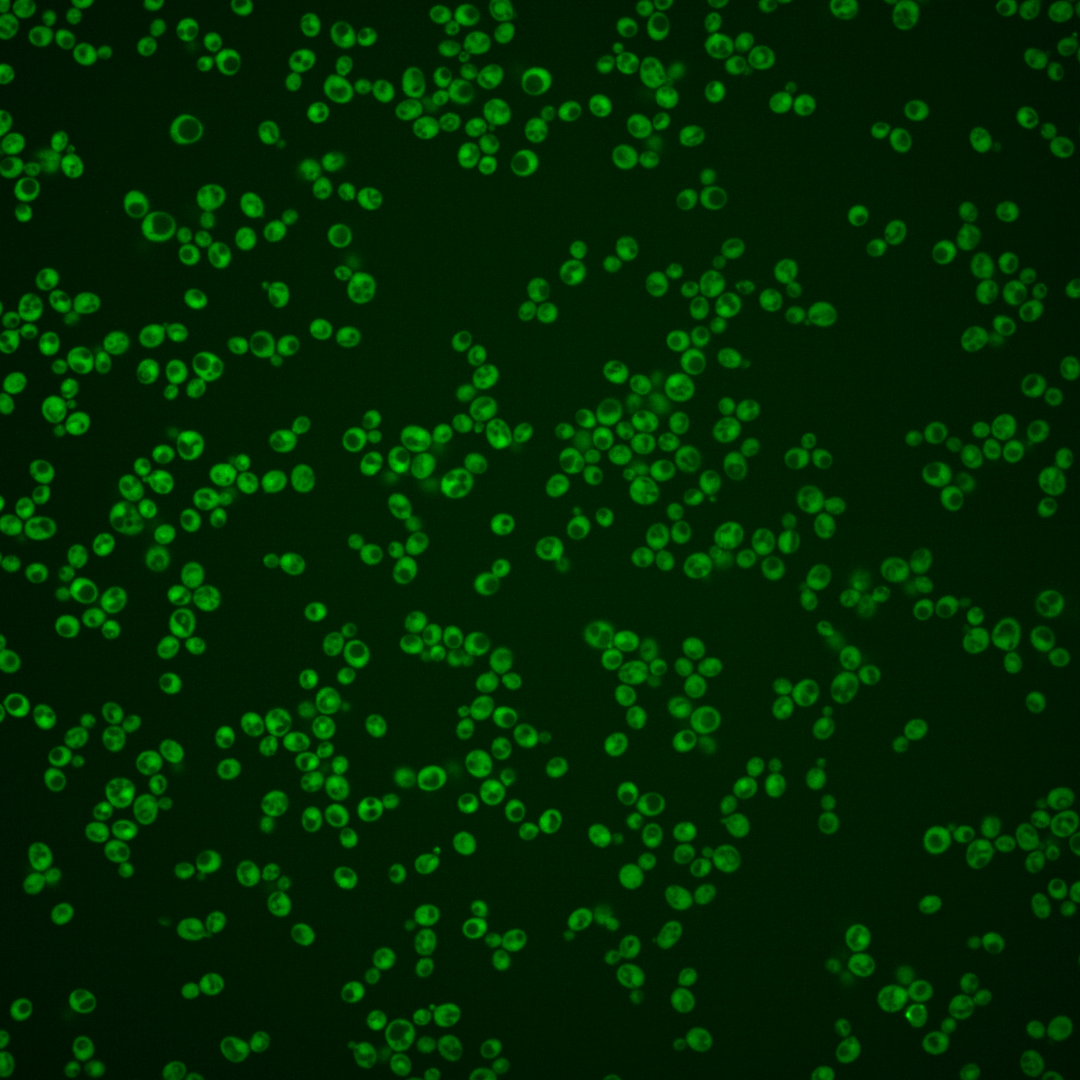
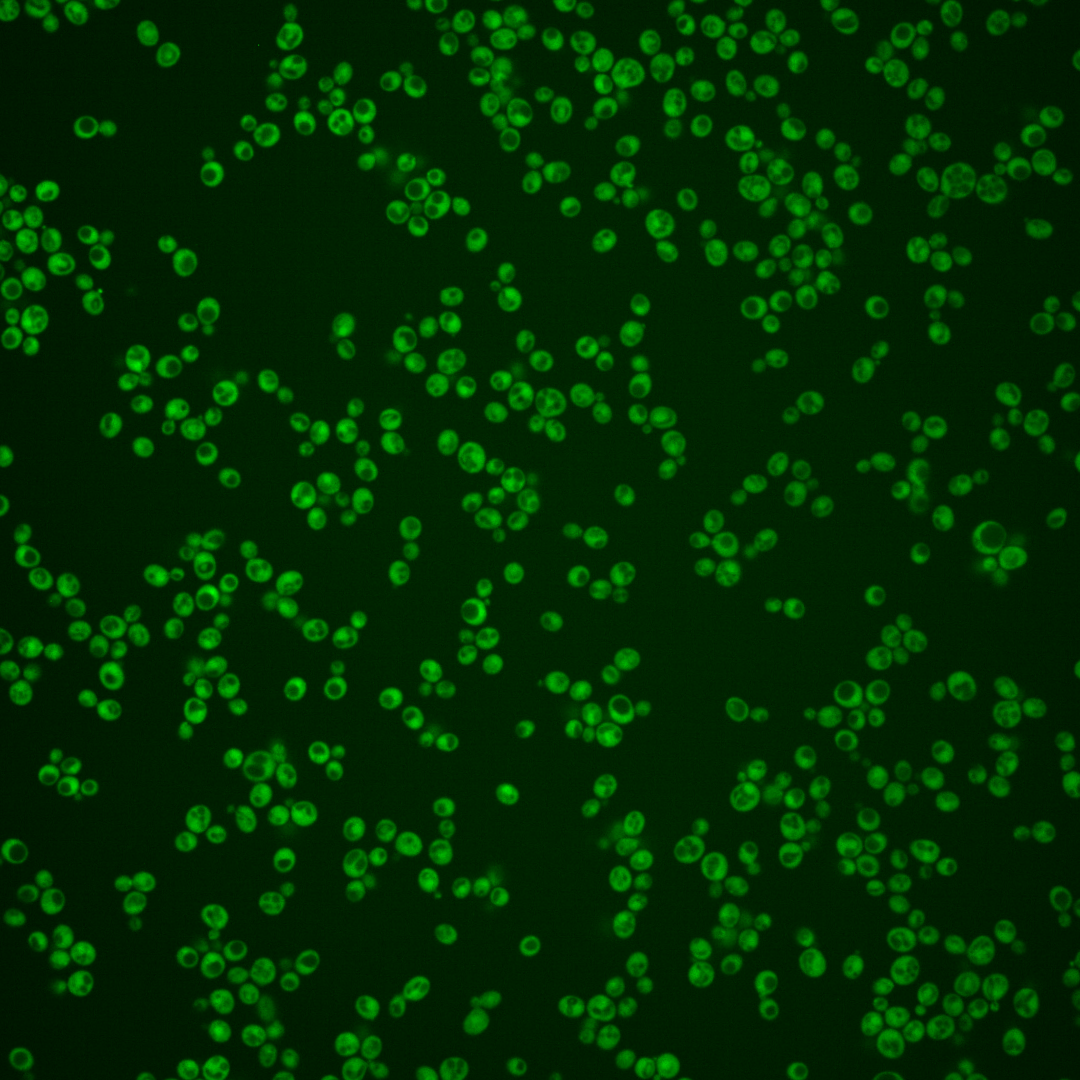
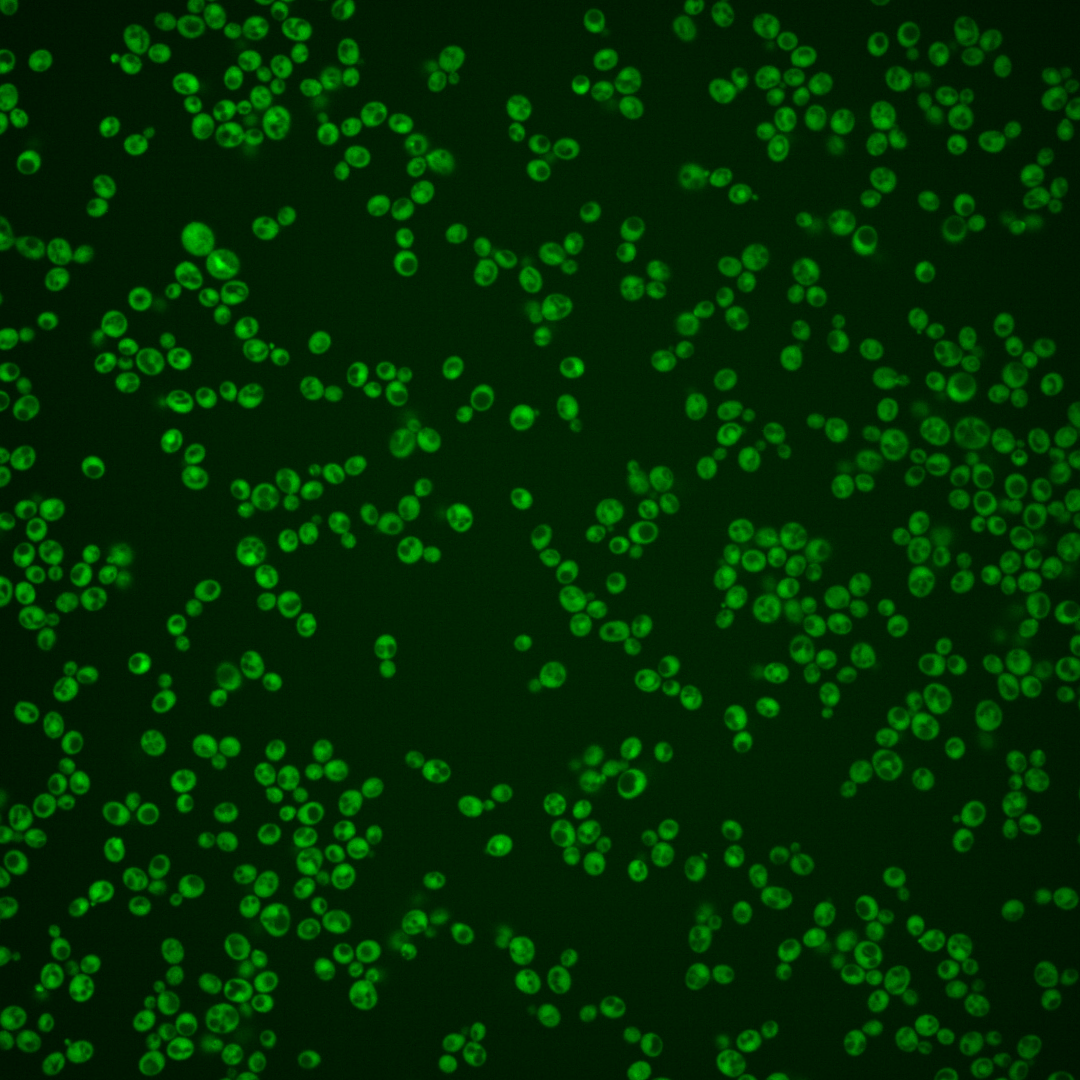

| Standard name | |
|---|---|
| Human Ortholog | |
| Description | RNA-binding protein that binds specific mRNAs and interacts with She3p; part of the mRNA localization machinery that restricts accumulation of certain proteins to the bud; binds to ER-derived membranes and targets mRNAs to cortical ER |
Micrographs




















































































Sub-cellular Localization
Yeast GFP Assignment
Protein Abundance
Localization Change
External localization resources
| ensLOC | DeepLoc | |||||||||||||||||||||||
|---|---|---|---|---|---|---|---|---|---|---|---|---|---|---|---|---|---|---|---|---|---|---|---|---|
| Localization | WT1 | WT2 | WT3 | RAP60 | RAP140 | RAP220 | RAP300 | RAP380 | RAP460 | RAP540 | RAP620 | RAP700 | HU80 | HU120 | HU160 | rpd3Δ_1 | rpd3Δ_2 | rpd3Δ_3 | WT1 | WT2 | WT3 | AF100 | AF140 | AF180 |
| Cortical Patches | 0 | 0 | 0 | 0 | 0 | 1 | 0 | 0 | 0 | 1 | 2 | 2 | 0 | 0 | 0 | 0 | 0 | 0 | 0 | 0 | 0 | 0 | 0 | 1 |
| Bud | 0 | 0 | 0 | 0 | 0 | 0 | 1 | 0 | 2 | 4 | 3 | 5 | 0 | 0 | 0 | 0 | 0 | 0 | 0 | 0 | 0 | 0 | 1 | 2 |
| Bud Neck | 0 | 0 | 0 | 0 | 0 | 0 | 0 | 0 | 0 | 0 | 0 | 0 | 0 | 0 | 0 | 0 | 0 | 0 | 0 | 0 | 0 | 0 | 0 | 0 |
| Bud Site | 0 | 0 | 0 | 0 | 0 | 0 | 0 | 0 | 0 | 0 | 0 | 0 | 0 | 0 | 0 | 0 | 0 | 0 | – | – | – | – | – | – |
| Cell Periphery | 0 | 0 | 1 | 0 | 0 | 4 | 3 | 2 | 0 | 0 | 2 | 4 | 0 | 0 | 0 | 2 | 1 | 1 | 0 | 0 | 0 | 0 | 0 | 0 |
| Cytoplasm | 128 | 225 | 133 | 149 | 167 | 166 | 166 | 136 | 88 | 136 | 166 | 190 | 85 | 221 | 265 | 198 | 182 | 143 | 131 | 232 | 141 | 158 | 191 | 229 |
| Endoplasmic Reticulum | 2 | 3 | 1 | 1 | 1 | 1 | 2 | 1 | 3 | 2 | 2 | 13 | 1 | 1 | 3 | 7 | 4 | 6 | 0 | 0 | 0 | 1 | 1 | 3 |
| Endosome | 0 | 0 | 0 | 0 | 0 | 2 | 0 | 0 | 0 | 2 | 2 | 3 | 0 | 0 | 0 | 0 | 1 | 1 | 1 | 1 | 1 | 1 | 0 | 2 |
| Golgi | 0 | 0 | 0 | 0 | 0 | 0 | 0 | 0 | 0 | 0 | 0 | 0 | 0 | 0 | 0 | 0 | 0 | 1 | 0 | 0 | 0 | 0 | 0 | 1 |
| Mitochondria | 0 | 3 | 0 | 0 | 0 | 10 | 22 | 10 | 33 | 45 | 68 | 73 | 1 | 0 | 0 | 7 | 5 | 0 | 0 | 3 | 2 | 1 | 1 | 0 |
| Nucleus | 0 | 0 | 3 | 2 | 4 | 4 | 11 | 10 | 4 | 8 | 13 | 11 | 1 | 1 | 3 | 5 | 6 | 6 | 0 | 2 | 2 | 3 | 9 | 9 |
| Nuclear Periphery | 0 | 1 | 0 | 0 | 0 | 0 | 1 | 0 | 0 | 0 | 0 | 1 | 1 | 0 | 0 | 0 | 0 | 0 | 0 | 0 | 0 | 0 | 1 | 0 |
| Nucleolus | 0 | 0 | 0 | 0 | 0 | 0 | 1 | 0 | 0 | 0 | 0 | 0 | 0 | 0 | 0 | 1 | 0 | 1 | 0 | 0 | 0 | 0 | 0 | 0 |
| Peroxisomes | 0 | 0 | 0 | 0 | 0 | 0 | 0 | 0 | 0 | 0 | 1 | 0 | 0 | 0 | 0 | 0 | 0 | 0 | 0 | 0 | 0 | 0 | 0 | 0 |
| SpindlePole | 0 | 0 | 0 | 0 | 0 | 0 | 0 | 0 | 0 | 0 | 1 | 0 | 0 | 0 | 0 | 0 | 0 | 0 | 0 | 0 | 0 | 0 | 0 | 0 |
| Vac/Vac Membrane | 2 | 4 | 3 | 16 | 25 | 21 | 43 | 31 | 19 | 23 | 25 | 23 | 1 | 21 | 32 | 47 | 44 | 28 | 1 | 4 | 1 | 3 | 1 | 4 |
| Unique Cell Count | 130 | 232 | 138 | 161 | 189 | 192 | 223 | 177 | 132 | 198 | 253 | 287 | 89 | 232 | 285 | 228 | 213 | 163 | 139 | 248 | 151 | 174 | 215 | 259 |
| Labelled Cell Count | 132 | 236 | 141 | 168 | 197 | 209 | 250 | 190 | 149 | 221 | 285 | 325 | 90 | 244 | 303 | 267 | 243 | 187 | 139 | 248 | 151 | 174 | 215 | 259 |
Yeast GFP Assignment
Protein Abundance
| Screen | WT1 | WT2 | WT3 | RAP60 | RAP140 | RAP220 | RAP300 | RAP380 | RAP460 | RAP540 | RAP620 | RAP700 | HU80 | HU120 | HU160 | rpd3Δ_1 | rpd3Δ_2 | rpd3Δ_3 | AF100 | AF140 | AF180 |
|---|---|---|---|---|---|---|---|---|---|---|---|---|---|---|---|---|---|---|---|---|---|
| Mean Cell GFP Intensity (1e-4) | 9.2 | 6.5 | 9.1 | 8.4 | 8.6 | 7.5 | 6.8 | 7.1 | 5.9 | 6.1 | 5.7 | 5.9 | 7.2 | 8.7 | 7.8 | 8.4 | 10.7 | 11.2 | 9.3 | 9.9 | 9.6 |
| Std Deviation (1e-4) | 1.3 | 1.0 | 1.0 | 1.2 | 1.4 | 1.8 | 1.7 | 1.7 | 1.0 | 1.4 | 1.0 | 1.1 | 1.3 | 1.4 | 1.1 | 1.6 | 2.0 | 2.2 | 1.4 | 1.4 | 1.5 |
| Intensity Change (Log2) | – | – | – | -0.12 | -0.08 | -0.28 | -0.41 | -0.37 | -0.63 | -0.58 | -0.67 | -0.63 | -0.34 | -0.07 | -0.22 | -0.11 | 0.22 | 0.3 | 0.03 | 0.11 | 0.08 |
Localization Change
| Localization | RAP60 | RAP140 | RAP220 | RAP300 | RAP380 | RAP460 | RAP540 | RAP620 | RAP700 | HU80 | HU120 | HU160 | rpd3Δ_1 | rpd3Δ_2 | rpd3Δ_3 |
|---|---|---|---|---|---|---|---|---|---|---|---|---|---|---|---|
| Cortical Patches | 0 | 0 | 0 | 0 | 0 | 0 | 0 | 0 | 0 | 0 | 0 | 0 | 0 | 0 | 0 |
| Bud | 0 | 0 | 0 | 0 | 0 | 0 | 0 | 0 | 0 | 0 | 0 | 0 | 0 | 0 | 0 |
| Bud Neck | 0 | 0 | 0 | 0 | 0 | 0 | 0 | 0 | 0 | 0 | 0 | 0 | 0 | 0 | 0 |
| Bud Site | 0 | 0 | 0 | 0 | 0 | 0 | 0 | 0 | 0 | 0 | 0 | 0 | 0 | 0 | 0 |
| Cell Periphery | 0 | 0 | 0 | 0 | 0 | 0 | 0 | 0 | 0 | 0 | 0 | 0 | 0 | 0 | 0 |
| Cytoplasm | -1.4 | -2.6 | -3.0 | -5.4 | -4.9 | -6.3 | -6.2 | -6.9 | -6.8 | -0.3 | -0.5 | -1.4 | -3.0 | -3.3 | -2.7 |
| Endoplasmic Reticulum | 0 | 0 | 0 | 0 | 0 | 0 | 0 | 0 | 0 | 0 | 0 | 0 | 0 | 0 | 0 |
| Endosome | 0 | 0 | 0 | 0 | 0 | 0 | 0 | 0 | 0 | 0 | 0 | 0 | 0 | 0 | 0 |
| Golgi | 0 | 0 | 0 | 0 | 0 | 0 | 0 | 0 | 0 | 0 | 0 | 0 | 0 | 0 | 0 |
| Mitochondria | 0 | 0 | 0 | 3.8 | 0 | 6.3 | 6.0 | 6.7 | 6.5 | 0 | 0 | 0 | 0 | 0 | 0 |
| Nucleus | 0 | 0 | 0 | 1.3 | 1.5 | 0 | 0 | 1.4 | 0 | 0 | 0 | 0 | 0 | 0 | 0 |
| Nuclear Periphery | 0 | 0 | 0 | 0 | 0 | 0 | 0 | 0 | 0 | 0 | 0 | 0 | 0 | 0 | 0 |
| Nucleolus | 0 | 0 | 0 | 0 | 0 | 0 | 0 | 0 | 0 | 0 | 0 | 0 | 0 | 0 | 0 |
| Peroxisomes | 0 | 0 | 0 | 0 | 0 | 0 | 0 | 0 | 0 | 0 | 0 | 0 | 0 | 0 | 0 |
| SpindlePole | 0 | 0 | 0 | 0 | 0 | 0 | 0 | 0 | 0 | 0 | 0 | 0 | 0 | 0 | 0 |
| Vacuole | 2.7 | 3.5 | 3.0 | 4.7 | 4.4 | 3.7 | 3.2 | 2.8 | 2.4 | 0 | 2.6 | 3.2 | 5.0 | 5.0 | 4.3 |
External localization resources
Images






























Protein Concentration and Protein Localization Data
| R1 | R2 | R3 | ||||||||||||||||
|---|---|---|---|---|---|---|---|---|---|---|---|---|---|---|---|---|---|---|
| G1 Pre-START | G1 Post-START | S/G2 | Metaphase | Anaphase | Telophase | G1 Pre-START | G1 Post-START | S/G2 | Metaphase | Anaphase | Telophase | G1 Pre-START | G1 Post-START | S/G2 | Metaphase | Anaphase | Telophase | |
| Concentration | 4.4831 | 5.7204 | 5.0765 | 5.3071 | 4.918 | 5.0834 | 7.0026 | 8.5138 | 7.458 | 7.0885 | 7.6553 | 8.355 | 4.8414 | 6.253 | 5.2723 | 5.8073 | 5.1104 | 5.7533 |
| Actin | 0.0006 | 0.0003 | 0.0008 | 0.0001 | 0.0002 | 0.0042 | 0.0375 | 0.001 | 0.0119 | 0.0008 | 0.0046 | 0.0048 | 0.0169 | 0.0006 | 0.0021 | 0.0003 | 0.0648 | 0.0068 |
| Bud | 0.0023 | 0.0001 | 0.0042 | 0.0001 | 0.0001 | 0.0001 | 0.001 | 0.0006 | 0.0006 | 0.0005 | 0.0004 | 0.0001 | 0.0005 | 0.0013 | 0.0001 | 0.0001 | 0.0002 | 0.0002 |
| Bud Neck | 0.0004 | 0.0002 | 0.0004 | 0.0004 | 0.0004 | 0.0013 | 0.0015 | 0.0002 | 0.0004 | 0.0004 | 0.0006 | 0.0014 | 0.0006 | 0.003 | 0.0004 | 0.0003 | 0.0004 | 0.0016 |
| Bud Periphery | 0.0006 | 0 | 0.0016 | 0 | 0 | 0 | 0.0014 | 0.0001 | 0.0003 | 0.0003 | 0.0001 | 0 | 0.0006 | 0.0014 | 0.0001 | 0 | 0.0001 | 0.0003 |
| Bud Site | 0.0006 | 0.0004 | 0.0005 | 0 | 0.0001 | 0.0001 | 0.0058 | 0.0012 | 0.0008 | 0.0007 | 0.0002 | 0.0001 | 0.0009 | 0.0021 | 0.0004 | 0 | 0.0003 | 0.0001 |
| Cell Periphery | 0.0001 | 0 | 0 | 0 | 0 | 0 | 0.0012 | 0.0001 | 0.0001 | 0 | 0 | 0 | 0.0001 | 0.0003 | 0 | 0 | 0 | 0 |
| Cytoplasm | 0.9446 | 0.9704 | 0.9519 | 0.9849 | 0.9673 | 0.95 | 0.7485 | 0.9586 | 0.9138 | 0.872 | 0.96 | 0.9527 | 0.9153 | 0.9632 | 0.9492 | 0.9809 | 0.9132 | 0.9437 |
| Cytoplasmic Foci | 0.0049 | 0.0032 | 0.0056 | 0.0023 | 0.0027 | 0.0057 | 0.0396 | 0.0013 | 0.0174 | 0.0301 | 0.0078 | 0.0071 | 0.0064 | 0.0035 | 0.0056 | 0.0013 | 0.0035 | 0.0043 |
| Eisosomes | 0 | 0 | 0 | 0 | 0 | 0.0001 | 0.0009 | 0 | 0 | 0 | 0 | 0 | 0.0001 | 0.0002 | 0 | 0 | 0.0001 | 0 |
| Endoplasmic Reticulum | 0.009 | 0.0026 | 0.0029 | 0.001 | 0.0018 | 0.004 | 0.0059 | 0.0007 | 0.0022 | 0.0026 | 0.0018 | 0.0015 | 0.0048 | 0.0031 | 0.0021 | 0.0079 | 0.0025 | 0.0021 |
| Endosome | 0.0049 | 0.0022 | 0.0026 | 0.0009 | 0.0086 | 0.01 | 0.0337 | 0.0003 | 0.0087 | 0.0279 | 0.0031 | 0.0053 | 0.0136 | 0.0029 | 0.0054 | 0.0017 | 0.0018 | 0.0029 |
| Golgi | 0.0002 | 0.0001 | 0.0002 | 0 | 0.0002 | 0.0028 | 0.0167 | 0.0001 | 0.0031 | 0.0027 | 0.0013 | 0.0027 | 0.0049 | 0.001 | 0.0008 | 0 | 0.002 | 0.0027 |
| Lipid Particles | 0.0001 | 0 | 0.0001 | 0 | 0 | 0.0005 | 0.0092 | 0 | 0.002 | 0.0013 | 0 | 0.0023 | 0.0015 | 0.0017 | 0.0055 | 0 | 0.0005 | 0.0044 |
| Mitochondria | 0.0003 | 0.0002 | 0.0003 | 0.0001 | 0.0003 | 0.0007 | 0.0042 | 0.0001 | 0.0013 | 0.0009 | 0.0005 | 0.0022 | 0.0031 | 0.0006 | 0.0018 | 0.0001 | 0.0005 | 0.0024 |
| None | 0.0123 | 0.0048 | 0.0043 | 0.002 | 0.0017 | 0.0076 | 0.0528 | 0.0338 | 0.0224 | 0.0507 | 0.0151 | 0.0089 | 0.014 | 0.0088 | 0.0037 | 0.0021 | 0.0017 | 0.0073 |
| Nuclear Periphery | 0.0057 | 0.0022 | 0.0021 | 0.0011 | 0.0024 | 0.0021 | 0.0044 | 0.0003 | 0.0017 | 0.001 | 0.0005 | 0.0013 | 0.003 | 0.0007 | 0.002 | 0.002 | 0.0006 | 0.0013 |
| Nucleolus | 0 | 0 | 0 | 0 | 0 | 0 | 0.0003 | 0 | 0.0001 | 0.0001 | 0 | 0.0001 | 0.0001 | 0.0001 | 0.0024 | 0 | 0 | 0 |
| Nucleus | 0.0105 | 0.0106 | 0.0204 | 0.0062 | 0.0102 | 0.0086 | 0.0076 | 0.0015 | 0.0045 | 0.0032 | 0.0023 | 0.0037 | 0.0089 | 0.0029 | 0.0055 | 0.0024 | 0.005 | 0.0095 |
| Peroxisomes | 0.0002 | 0.0001 | 0.0002 | 0 | 0 | 0.0002 | 0.0158 | 0 | 0.0049 | 0.0011 | 0.0009 | 0.0034 | 0.0008 | 0.0005 | 0.0068 | 0 | 0.0019 | 0.0087 |
| Punctate Nuclear | 0.0008 | 0.0014 | 0.001 | 0.0002 | 0.0004 | 0.0006 | 0.0076 | 0.0001 | 0.0032 | 0.0013 | 0.0004 | 0.0017 | 0.0007 | 0.0002 | 0.005 | 0.0001 | 0.0002 | 0.0009 |
| Vacuole | 0.0016 | 0.0009 | 0.0008 | 0.0005 | 0.0029 | 0.0009 | 0.0031 | 0.0001 | 0.0005 | 0.0017 | 0.0002 | 0.0004 | 0.0023 | 0.0017 | 0.0009 | 0.0006 | 0.0004 | 0.0005 |
| Vacuole Periphery | 0.0003 | 0.0001 | 0.0002 | 0.0001 | 0.0007 | 0.0004 | 0.0012 | 0 | 0.0002 | 0.0005 | 0.0001 | 0.0002 | 0.0009 | 0.0002 | 0.0002 | 0.0002 | 0.0001 | 0.0002 |
Sequencing Data
| R1 | R2 | |||||||||
|---|---|---|---|---|---|---|---|---|---|---|
| G1 Post-START | S/G2 | Metaphase | Anaphase | Telophase | G1 Post-START | S/G2 | Metaphase | Anaphase | Telophase | |
| Gene Expression | 22.3361 | 59.9014 | 31.6085 | 26.8229 | 16.4105 | 16.3708 | 33.9844 | 35.8819 | 24.6573 | 20.0292 |
| Translational Efficiency | 1.5916 | 1.1225 | 1.9092 | 1.6356 | 1.884 | 1.6404 | 1.5611 | 1.6307 | 2.1086 | 1.5351 |
Hit Data
| Dataset | Hit |
|---|---|
| Protein Concentration | ✘ |
| Protein Localization | ✘ |
| Gene Expression | ✔ |
| Translational Efficiency | ✘ |
Endocytosis
| Temp | Actin Patch (Sac6-tdTomato) | Cortical Patch (Sla1-GFP) | Late Endosome (Snf7-GFP) | Vacuole (Vph1-GFP) |
|---|---|---|---|---|
| 37℃ | ||||
| RT |
Cell Cycle Omics
CYCLoPs (She2-GFP)
| Gene / Allele | Actin Patch (Sac6-tdTomato) | Cortical Patch (Sla1-GFP) | Late Endosome (Snf7-GFP) | Vacuole (Sac6-tdTomato) |
|---|
| Gene | Images |
|---|
| Gene | Images |
|---|
Images are not yet available
Images are not yet available